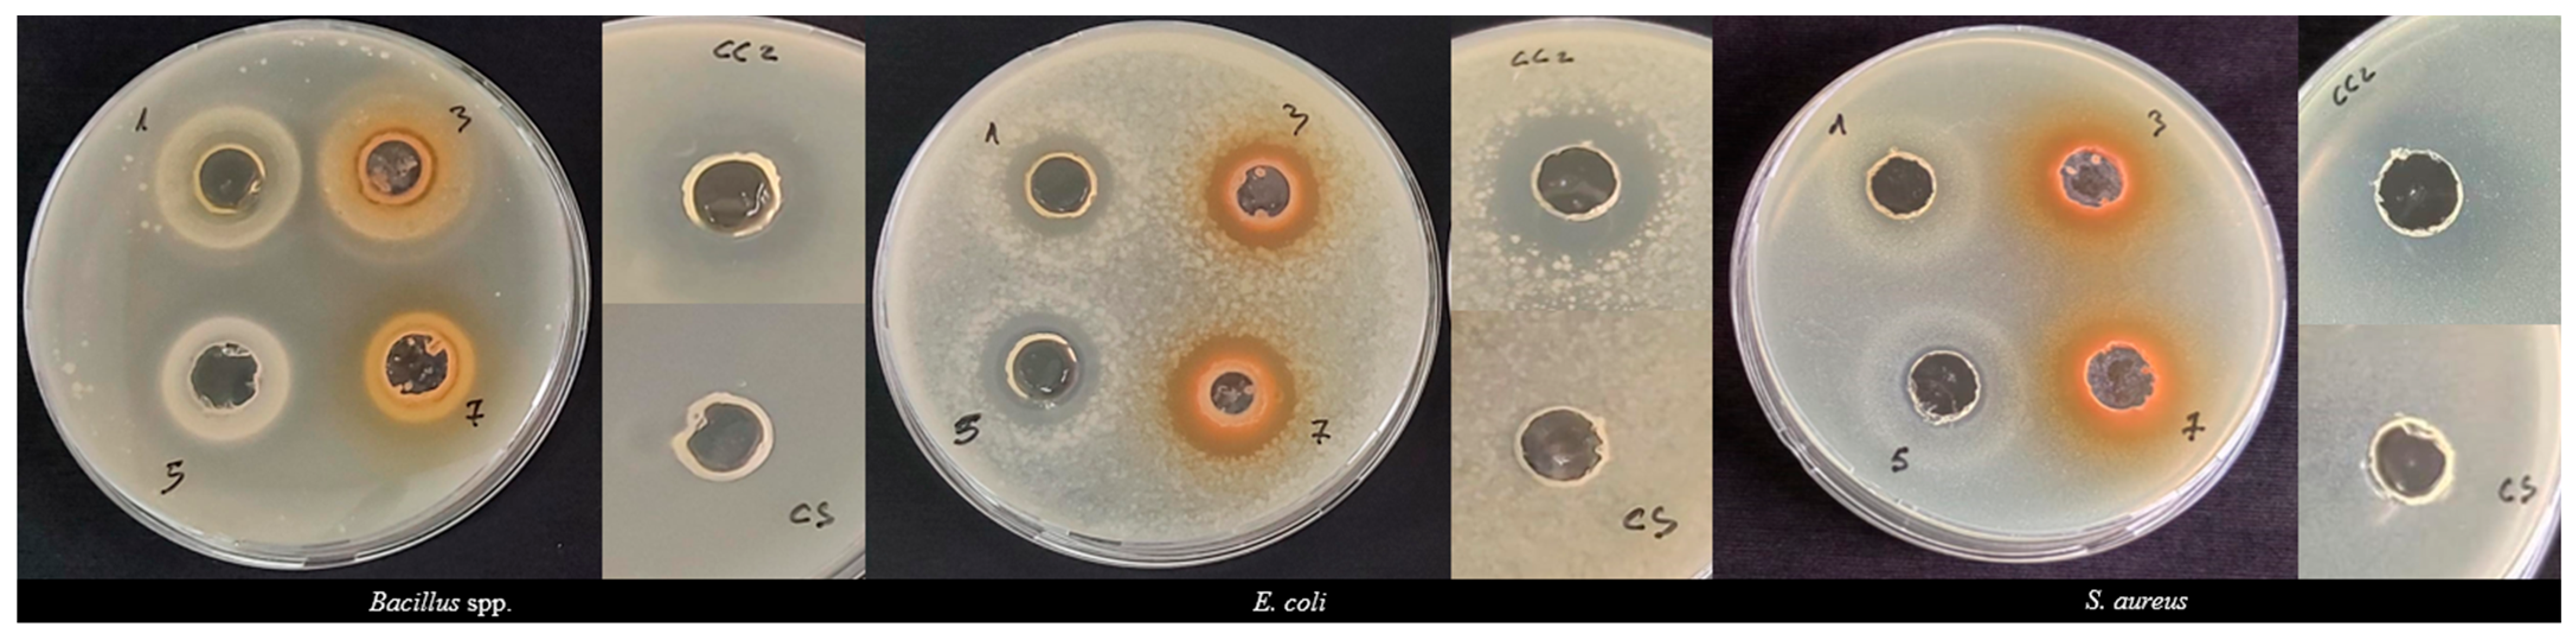
Antioxidants 13 00345 g003

Phytochemical Characterization and Antibacterial Activity of Albanian Juniperus communis and Juniperus oxycedrus Berries and Needle Leaves Extracts
Abstract
1. Introduction
2. Materials and Methods
2.1. Plant Materials
2.2. Reagents
2.3. Ultrasound-Assisted Extraction
2.4. Determination of Total Phenolic Content (TPC), Total Flavonoid Content (TFC), and Total Anthocyanin Content (TAC) of the Extracts
2.5. Antioxidant Activity of the Extracts
2.6. Chromatographic Analysis of the Extracts
2.7. In Vitro Antibacterial Activity
2.7.1. Microorganisms Used
2.7.2. Agar Well Diffusion Assay
2.7.3. Minimum Inhibitory Concentration and Minimum Bactericidal Concentration
2.8. Statistical Analysis
3. Results
3.1. Extraction Yield of the Extracts
3.2. Phytochemical Characterization and Antioxidant Activity of the Extracts
3.3. HPLC Phytochemical Profile of the Extracts
3.4. Antibacterial Activity
3.4.1. Agar Well Diffusion Assay
3.4.2. Minimum Inhibitory Concentration and Minimum Bactericidal Concentration
4. Discussion
5. Conclusions
Author Contributions
Funding
Data Availability Statement
Acknowledgments
Conflicts of Interest
References
- Cvjetko Bubalo, M.; Vidović, S.; Radojčić Redovniković, I.; Jokić, S. New Perspective in Extraction of Plant Biologically Active Compounds by Green Solvents. Food Bioprod. Process. 2018, 109, 52–73. [Google Scholar] [CrossRef]
- Tavares, W.; Seca, A. The Current Status of the Pharmaceutical Potential of Juniperus L. Metabolites. Medicines 2018, 5, 81. [Google Scholar] [CrossRef]
- Mickymaray Efficacy and Mechanism of Traditional Medicinal Plants and Bioactive Compounds against Clinically Important Pathogens. Antibiotics 2019, 8, 257. [CrossRef]
- European Medicines Agency. Assessment Report Juniperus Communis Aetheroleum. 2010. Available online: https://www.ema.europa.eu/en/documents/herbal-report/final-assessment-report-juniperus-communis-l-aetheroleum_en.pdf (accessed on 28 February 2024).
- Code of Federal Regulation. 21 CFR Part 182–Substances Generally Recognized as Safe (4–1–23 Edition). 2023. Available online: https://www.govinfo.gov/content/pkg/CFR-2023-title21-vol3/pdf/CFR-2023-title21-vol3-part182.pdf (accessed on 28 February 2024).
- Judžentienė, A. Juniperus communis L.: A Review of Volatile Organic Compounds of Wild and Cultivated Common Juniper in Lithuania. Chemija 2019, 30, 184–193. [Google Scholar] [CrossRef]
- Raina, R.; Verma, P.K.; Peshin, R.; Kour, H. Potential of Juniperus Communis L as a Nutraceutical in Human and Veterinary Medicine. Heliyon 2019, 5, e02376. [Google Scholar] [CrossRef]
- Adams, D.R.P. Junipers of the World: The Genus Juniperus, 4th ed.; Trafford Publishing: Bloomington, IN, USA, 2014; pp. 2, 9–10; ISBN 978-1-4907-2325-9. [Google Scholar]
- Pazari, F. Vlerësimi Ekonomik dhe Ekologjik i Bimëve Mjekësore dhe Aromatike të Shqipërisë në Funksion të Zhvillimit të Ekonomisë Rurale. Ph.D. Thesis, University of Tirana, Faculty of History and Philology, Tirana, Albania, 2014. pp. 30, 33, 148. Available online: https://www.unitir.edu.al/wp-content/uploads/2014/11/Doktoratura-Florina-Pazari-Fakulteti-i-Historise-dhe-i-Filologjise-Departamenti-i-Gjeografise.pdf (accessed on 10 March 2024).
- AGT. DSA. Medicinal and Aromatic Plants Sector Study. 2017.2192.7-001.00. 2017. Available online: https://bujqesia.gov.al/wp-content/uploads/2021/12/04-MAP-Sector-Study_FINAL.pdf (accessed on 28 February 2024).
- Abdallah, E.M.; Alhatlani, B.Y.; De Paula Menezes, R.; Martins, C.H.G. Back to Nature: Medicinal Plants as Promising Sources for Antibacterial Drugs in the Post-Antibiotic Era. Plants 2023, 12, 3077. [Google Scholar] [CrossRef]
- Abubakar, A.; Haque, M. Preparation of Medicinal Plants: Basic Extraction and Fractionation Procedures for Experimental Purposes. J. Pharm. Bioall. Sci. 2020, 12, 1. [Google Scholar] [CrossRef]
- Chuo, S.C.; Nasir, H.M.; Mohd-Setapar, S.H.; Mohamed, S.F.; Ahmad, A.; Wani, W.A.; Muddassir, M.; Alarifi, A. A Glimpse into the Extraction Methods of Active Compounds from Plants. Crit. Rev. Anal. Chem. 2022, 52, 667–696. [Google Scholar] [CrossRef]
- Belov, T.; Terenzhev, D.; Bushmeleva, K.N.; Davydova, L.; Burkin, K.; Fitsev, I.; Gatiyatullina, A.; Egorova, A.; Nikitin, E. Comparative Analysis of Chemical Profile and Biological Activity of Juniperus communis L. Berry Extracts. Plants 2023, 12, 3401. [Google Scholar] [CrossRef]
- Medda, S.; Fadda, A.; Dessena, L.; Mulas, M. Quantification of Total Phenols, Tannins, Anthocyanins Content in Myrtus communis L. and Antioxidant Activity Evaluation in Function of Plant Development Stages and Altitude of Origin Site. Agronomy 2021, 11, 1059. [Google Scholar] [CrossRef]
- Serea, D.; Constantin, O.E.; Horincar, G.; Stănciuc, N.; Aprodu, I.; Bahrim, G.E.; Râpeanu, G. Optimization of Extraction Parameters of Anthocyanin Compounds and Antioxidant Properties from Red Grape (Băbească Neagră) Peels. Inventions 2023, 8, 59. [Google Scholar] [CrossRef]
- Yangui, I.; Younsi, F.; Ghali, W.; Boussaid, M.; Messaoud, C. Phytochemicals, Antioxidant and Anti-Proliferative Activities of Myrtus communis L. Genotypes from Tunisia. S. Afr. J. Bot. 2021, 137, 35–45. [Google Scholar] [CrossRef]
- Sethi, S.; Joshi, A.; Arora, B.; Bhowmik, A.; Sharma, R.R.; Kumar, P. Significance of FRAP, DPPH, and CUPRAC Assays for Antioxidant Activity Determination in Apple Fruit Extracts. Eur. Food Res. Technol. 2020, 246, 591–598. [Google Scholar] [CrossRef]
- Labri, K.; Moghrani, H.; Kord, A.; Doukara, A.; Gueffai, A.; Assia, A. Phytochemical Screening, Antioxidant and Antimicrobial Activities of Grape (Vitis vinifera L.) Seed Extracts from Red Globe and Valenci Algerian Varieties. Acta Period. Technol. 2020, 220, 137–147. [Google Scholar] [CrossRef]
- Dumitrașcu, L.; Lanciu (Dorofte), A.; Aprodu, I. A Preliminary Study on Using Ultrasounds for the Valorization of Spent Brewer’s Yeast. AUDJG-Food Technol. 2022, 46, 141–153. [Google Scholar] [CrossRef]
- Blejan, A.M.; Nour, V.; Păcularu-Burada, B.; Popescu, S.M. Wild Bilberry, Blackcurrant, and Blackberry by-Products as a Source of Nutritional and Bioactive Compounds. Int. J. Food Prop. 2023, 26, 1579–1595. [Google Scholar] [CrossRef]
- Masota, N.E.; Vogg, G.; Ohlsen, K.; Holzgrabe, U. Reproducibility Challenges in the Search for Antibacterial Compounds from Nature. PLoS ONE 2021, 16, e0255437. [Google Scholar] [CrossRef] [PubMed]
- Hannan, A.; Asghar, S.; Tahir, N.; Ikram Ullah, M.; Ahmed, I.; Aneela, S.; Hussain, S. Antibacterial Effect of Mango (Mangifera Indica Linn.) Leaf Extract against Antibiotic Sensitive and Multi-Drug Resistant Salmonella Typhi. Pak. J. Pharm. Sci. 2013, 26, 715–719. [Google Scholar] [PubMed]
- Farahmandfar, R.; Esmaeilzadeh Kenari, R.; Asnaashari, M.; Shahrampour, D.; Bakhshandeh, T. Bioactive Compounds, Antioxidant and Antimicrobial Activities of Arum maculatum Leaves Extracts as Affected by Various Solvents and Extraction Methods. Food Sci. Nutr. 2019, 7, 465–475. [Google Scholar] [CrossRef] [PubMed]
- Alshareef, F. Protocol to Evaluate Antibacterial Activity MIC, FIC and Time Kill Method. Acta Sci. Microbiol. 2021, 4, 2–6. [Google Scholar] [CrossRef]
- Parvekar, P.; Palaskar, J.; Metgud, S.; Maria, R.; Dutta, S. The Minimum Inhibitory Concentration (MIC) and Minimum Bactericidal Concentration (MBC) of Silver Nanoparticles against Staphylococcus aureus. Biomater. Investig. Dent. 2020, 7, 105–109. [Google Scholar] [CrossRef]
- Platzer, M.; Kiese, S.; Herfellner, T.; Schweiggert-Weisz, U.; Miesbauer, O.; Eisner, P. Common Trends and Differences in Antioxidant Activity Analysis of Phenolic Substances Using Single Electron Transfer Based Assays. Molecules 2021, 26, 1244. [Google Scholar] [CrossRef]
- Bale, B.I.; Elebesunu, E.E.; Manikavasagar, P.; Agwuna, F.O.; Ogunkola, I.O.; Sow, A.U.; Lucero-Prisno, D.E. Antibiotic Resistance in Ocular Bacterial Infections: An Integrative Review of Ophthalmic Chloramphenicol. Trop. Med. Health 2023, 51, 15. [Google Scholar] [CrossRef] [PubMed]
- Nguyen, L.M.; Nguyen, N.T.T.; Nguyen, T.T.T.; Nguyen, T.T.; Nguyen, D.T.C.; Tran, T.V. Occurrence, Toxicity and Adsorptive Removal of the Chloramphenicol Antibiotic in Water: A Review. Environ. Chem. Lett. 2022, 20, 1929–1963. [Google Scholar] [CrossRef] [PubMed]
- Meringolo, L.; Bonesi, M.; Sicari, V.; Rovito, S.; Passalacqua, N.G.; Loizzo, M.R.; Tundis, R. Essential Oils and Extracts of Juniperus Macrocarpa Sm. and Juniperus oxycedrus L.: Comparative Phytochemical Composition and Anti-Proliferative and Antioxidant Activities. Plants 2022, 11, 1025. [Google Scholar] [CrossRef]
- Orhan, N.; Orhan, I.E.; Ergun, F. Insights into Cholinesterase Inhibitory and Antioxidant Activities of Five Juniperus Species. Food Chem. Toxicol. 2011, 49, 2305–2312. [Google Scholar] [CrossRef]
- Popescu, D.; Botoran, O.; Cristea, R.; Mihăescu, C.; Șuțan, N. Effects of Geographical Area and Harvest Times on Chemical Composition and Antibacterial Activity of Juniperus communis L. Pseudo-Fruits Extracts: A Statistical Approach. Horticulturae 2023, 9, 325. [Google Scholar] [CrossRef]
- Fejér, J.; Gruľová, D.; Eliašová, A.; Kron, I. Seasonal Variability of Juniperus communis L. Berry Ethanol Extracts: 2. In Vitro Ferric Reducing Ability of Plasma (FRAP) Assay. Molecules 2022, 27, 9027. [Google Scholar] [CrossRef]
- Mrid, R.B.; Bouchmaa, N.; Bouargalne, Y.; Ramdan, B.; Karrouchi, K.; Kabach, I.; Karbane, M.E.; Idir, A.; Zyad, A.; Nhiri, M. Phytochemical Characterization, Antioxidant and In Vitro Cytotoxic Activity Evaluation of Juniperus oxycedrus Subsp. oxycedrus Needles and Berries. Molecules 2019, 24, 502. [Google Scholar] [CrossRef]
- Fierascu, I.; Ungureanu, C.; Avramescu, S.M.; Cimpeanu, C.; Georgescu, M.I.; Fierascu, R.C.; Ortan, A.; Sutan, A.N.; Anuta, V.; Zanfirescu, A.; et al. Genoprotective, Antioxidant, Antifungal and Anti-Inflammatory Evaluation of Hydroalcoholic Extract of Wild-Growing Juniperus communis L. (Cupressaceae) Native to Romanian Southern Sub-Carpathian Hills. BMC Complement. Altern. Med. 2018, 18, 3. [Google Scholar] [CrossRef]
- Marchiosi, R.; Dos Santos, W.D.; Constantin, R.P.; De Lima, R.B.; Soares, A.R.; Finger-Teixeira, A.; Mota, T.R.; De Oliveira, D.M.; Foletto-Felipe, M.D.P.; Abrahão, J.; et al. Biosynthesis and Metabolic Actions of Simple Phenolic Acids in Plants. Phytochem. Rev. 2020, 19, 865–906. [Google Scholar] [CrossRef]
- Xu, S.; Li, X.; Liu, S.; Tian, P.; Li, D. Juniperus sabina L. as a Source of Podophyllotoxins: Extraction Optimization and Anticholinesterase Activities. Int. J. Mol. Sci. 2022, 23, 10205. [Google Scholar] [CrossRef] [PubMed]
- Kahkeshani, N.; Farzaei, F.; Fotouhi, M.; Alavi, S.S.; Bahramsoltani, R.; Naseri, R.; Momtaz, S.; Abbasabadi, Z.; Rahimi, R.; Farzaei, M.H.; et al. Pharmacological Effects of Gallic Acid in Health and Diseases: A Mechanistic Review. Iran. J. Basic Med. Sci. 2019, 22, 225–237. [Google Scholar] [CrossRef] [PubMed]
- Kaur, J.; Kaur, R. P-Coumaric Acid: A Naturally Occurring Chemical with Potential Therapeutic Applications. Curr. Org. Chem. 2022, 26, 1333–1349. [Google Scholar] [CrossRef]
- Kaur, J.; Gulati, M.; Singh, S.K.; Kuppusamy, G.; Kapoor, B.; Mishra, V.; Gupta, S.; Arshad, M.F.; Porwal, O.; Jha, N.K.; et al. Discovering Multifaceted Role of Vanillic Acid beyond Flavours: Nutraceutical and Therapeutic Potential. Trends Food Sci. Technol. 2022, 122, 187–200. [Google Scholar] [CrossRef]
- Espíndola, K.M.M.; Ferreira, R.G.; Narvaez, L.E.M.; Silva Rosario, A.C.R.; da Silva, A.H.M.; Silva, A.G.B.; Vieira, A.P.O.; Monteiro, M.C. Chemical and Pharmacological Aspects of Caffeic Acid and Its Activity in Hepatocarcinoma. Front. Oncol. 2019, 9, 541. [Google Scholar] [CrossRef]
- Shan, Z.; Nisar, M.F.; Li, M.; Zhang, C.; Wan, C. (Craig) Theaflavin Chemistry and Its Health Benefits. Oxid. Med. Cell Longev. 2021, 2021, 6256618. [Google Scholar] [CrossRef] [PubMed]
- Singh, D.; Kumari, K.; Ahmed, S. CHAPTER 17—Natural Herbal Products for Cancer Therapy. In Understanding Cancer; Jain, B., Pandey, S., Eds.; Academic Press: Cambridge, MA, USA, 2022; pp. 257–268. ISBN 978-0-323-99883-3. [Google Scholar]
- Song, J.; He, Y.; Luo, C.; Feng, B.; Ran, F.; Xu, H.; Ci, Z.; Xu, R.; Han, L.; Zhang, D. New Progress in the Pharmacology of Protocatechuic Acid: A Compound Ingested in Daily Foods and Herbs Frequently and Heavily. Pharmacol. Res. 2020, 161, 105109. [Google Scholar] [CrossRef]
- Hayeshi, R.; Mutingwende, I.; Mavengere, W.; Masiyanise, V.; Mukanganyama, S. The Inhibition of Human Glutathione S-Transferases Activity by Plant Polyphenolic Compounds Ellagic Acid and Curcumin. Food Chem. Toxicol. 2007, 45, 286–295. [Google Scholar] [CrossRef]
- Ertürk, Ö. Antibacterial and Antifungal Activity of Ethanolic Extracts from Eleven Spice Plants. Biologia 2006, 61, 275–278. [Google Scholar] [CrossRef]
- Esteban, L.S.; Mediavilla, I.; Xavier, V.; Amaral, J.S.; Pires, T.C.S.P.; Calhelha, R.C.; López, C.; Barros, L. Yield, Chemical Composition and Bioactivity of Essential Oils from Common Juniper (Juniperus communis L.) from Different Spanish Origins. Molecules 2023, 28, 4448. [Google Scholar] [CrossRef]
- Ndhlala, A.R.; Amoo, S.O.; Ncube, B.; Moyo, M.; Nair, J.J.; Van Staden, J. 16-Antibacterial, Antifungal, and Antiviral Activities of African Medicinal Plants. In Medicinal Plant Research in Africa; Kuete, V., Ed.; Elsevier: Oxford, UK, 2013; pp. 621–659. ISBN 978-0-12-405927-6. [Google Scholar]
- Semerdjieva, I.; Zheljazkov, V.D.; Radoukova, T.; Radanović, D.; Marković, T.; Dincheva, I.; Stoyanova, A.; Astatkie, T.; Kačániová, M. Essential Oil Yield, Composition, Bioactivity and Leaf Morphology of Juniperus oxycedrus L. from Bulgaria and Serbia. Biochem. Syst. Ecol. 2019, 84, 55–63. [Google Scholar] [CrossRef]
- Semerdjieva, I.B.; Zheljazkov, V.D.; Dincheva, I.; Astatkie, T.; Kačániová, M. Chemotypes of Juniperus oxycedrus in Bulgaria and the Antimicrobial Activity of Galbuli Essential Oils. Ind. Crop. Prod. 2020, 158, 113005. [Google Scholar] [CrossRef]
- Breijyeh, Z.; Jubeh, B.; Karaman, R. Resistance of Gram-Negative Bacteria to Current Antibacterial Agents and Approaches to Resolve It. Molecules 2020, 25, 1340. [Google Scholar] [CrossRef]
- Rajouani, N.; Benyamna, A.; Romane, A.; Bouamama, H.; Chernane, H.; Falconieri, D.; Procedda, S.; Marongiu, B. Chemical Composition, Antioxidant and Antibacterial Activity of Juniperus oxycedrus Subsp. Oxycedrus L. Berry, Essential Oil from Morocco. J. Appl. Chem. Environ. Prot. 2015, 1, 9–19. [Google Scholar]
- Haziri, A.; Faiku, F.; Mehmeti, A.; Govori, S.; Abazi, S.; Daci, M.; Haziri, I.; Bytyqi-Damoni, A.; Mele, A. Antimicrobial Properties of the Essential Oil of Juniperus communis (L.) Growing Wild in East Part of Kosovo. Am. J. Pharmacol. Toxicol. 2013, 8, 128–133. [Google Scholar] [CrossRef]

| Moisture Content | Water Activity | Extraction Yield | |||
|---|---|---|---|---|---|
| % | aw | EtA | Et | ||
| % | % | ||||
| Berries | J. communis | 14.73 ± 0.00 | 0.52 ± 0.00 | 54.21 | - |
| J. oxycedrus | 18.75 ± 0.00 | 0.64 ± 0.00 | 54.40 | - | |
| Leaves | J. communis | 8.06 ± 0.00 | 0.26 ± 0.00 | - | 24.20 |
| J. oxycedrus | 8.13 ± 0.00 | 0.24 ± 0.00 | - | 30.19 | |
| Berries | Leaves | |||
|---|---|---|---|---|
| J. communis | J. oxycedrus | J. communis | J. oxycedrus | |
| TPC (mg GAE/g DW) | 3.04 ± 0.09 A | 2.12 ± 0.05 B | 9.57 ± 0.99 a | 10.98 ± 0.58 a |
| TFC (mg QE/g DW) | 1.14 ± 0.36 A | 0.17 ± 0.09 B | 7.79 ± 0.08 b | 10.55 ± 0.24 a |
| TAC (µg C3GE/g DW) | 3.46 ± 0.00 B | 79.04 ± 0.00 A | n.d. | n.d. |
| DPPH (mmol TE/g DW) | 0.07 ± 0.01 A | 0.02 ± 0.00 B | 0.29 ± 0.03 a | 0.33 ± 0.00 a |
| ABTS (mmol TE/g DW) | 0.21 ± 0.01 A | 0.06 ± 0.00 B | 1.67 ± 0.01 b | 1.83 ± 0.01 a |
| Bioactive Compound (µg/g Extract) | Berries | Leaves | ||
|---|---|---|---|---|
| J. communis | J. oxycedrus | J. communis | J. oxycedrus | |
| (−)—Epigallocatechin | n.d. | n.d. | n.d. | 1129.23 ± 3.66 B |
| Apigenin | 2.67 ± 0.00 BC, B | 3.17 ± 0.01 K, A | n.d. | n.d. |
| Caffeic acid | n.d. | n.d. | 3.45 ± 0.19 O, b | 85.98 ± 0.28 D, a |
| Caffeine | n.d. | n.d. | 5.09 ± 0.05 M, b | 12.44 ± 0.08 L, a |
| Catechin | 93.98 ± 0.37 A | n.d. | n.d. | n.d. |
| Chlorogenic acid | n.d. | 10.74 ± 0.37 F | n.d. | n.d. |
| Ellagic acid | 0.02 ± 0.00 C, B | 445.69 ± 0.96 A, A | 8133.83 ± 4.03 A, a | 2890.05 ± 0.29 A, b |
| Epicatechin gallate | 8.00 ± 0.03 BC | n.d. | n.d. | n.d. |
| Ferulic acid | n.d. | n.d. | 23.66 ± 0.52 E, b | 87.84 ± 0.21 C, a |
| Gallic acid | n.d. | 290.23 ± 0.13 B | 38.28 ± 0.01 D | n.d. |
| Hesperidin | n.d. | n.d. | 6.04 ± 0.95 L | n.d. |
| Kaempferol | 10.83 ± 0.40 B, B | 63.30 ± 0.91 C, A | 179.87 ± 2.26 B, a | 57.76 ± 9.47 F, b |
| Luteolin | n.d. | 5.26 ± 0.08 H | 8.02 ± 0.40 H, a | 5.35 ± 0.66 O, b |
| Myricetin | n.d. | 28.24 ± 4.57 D | n.d. | 22.15 ± 0.19 I |
| Naringin | n.d. | n.d. | 12.13 ± 0.06 F, a | 8.26 ± 0.14 N, b |
| p-Coumaric acid | n.d. | n.d. | n.d. | 12.73 ± 0.09 K |
| Procyanidin A1 | n.d. | 26.18 ± 0.06 E | 40.83 ± 0.09 C, b | 81.82 ± 0.05 E, a |
| Protocatechuic acid | 8.20 ± 1.16 BC | n.d. | 7.55 ± 0.09 J, b | 15.80 ± 0.75 J, a |
| Quercetin 3-D-galactoside | 6.07 ± 0.08 BC, A | 1.09 ± 0.03 L, B | n.d. | 56.45 ± 0.66 G |
| Quercetin 3-glucoside | n.d. | 5.05 ± 0.05 I | 7.17 ± 0.18 K, a | 2.52 ± 0.29 P, b |
| Quercetin 3-β-D-glucoside | n.d. | n.d. | 9.38 ± 0.11 G | n.d. |
| Syringic acid | 5.75 ± 0.02 BC | n.d. | 3.86 ± 0.01 N, b | 8.62 ± 0.02 M, a |
| Theaflavin | 2.74 ± 0.04 BC, B | 3.75 ± 0.02 J, A | n.d. | n.d. |
| Vanillic acid | n.d. | 9.88 ± 0.02 G | 7.66 ± 0.04 I, b | 23.21 ± 0.16 H, a |
| Diameter Inhibition Zone (mm)/Tested Bacterial Strains | ||||
|---|---|---|---|---|
| Bacillus spp. | E. coli | S. aureus | ||
| Berries | J. communis | 25.75 ± 3.89 A, A | 17.50 ± 0.71 B, A | 26.00 ± 1.41 A, A |
| J. oxycedrus | 20.25 ± 0.35 A, B | 19.00 ± 1.41 AB, B | 26.50 ± 2.12 A, A | |
| Leaves | J. communis | 23.50 ± 2.12 a, a | 18.50 ± 0.71 b, a | 18.50 ± 0.71 b, a |
| J. oxycedrus | 17.50 ± 0.71 a, b | 20.75 ± 0.35 ab, a | 19.50 ± 0.71 b, ab | |
| Controls | Chloramphenicol | 22.00 ± 1.41 A, a | 22.00 ± 0.71 A, a | 30.00 ± 0.71 A, a |
| Solvent | n.d. | n.d. | n.d. | |
| MIC (mg/mL) | MBC (mg/mL) | ||||||
|---|---|---|---|---|---|---|---|
| Bacillus spp. | E. coli | S. aureus | Bacillus spp. | E. coli | S. aureus | ||
| Berries | J. communis | 0.05 | 6.25 | 6.25 | 12.50 | 12.50 | 12.50 |
| J. oxycedrus | 0.05 | 6.25 | 6.25 | 12.50 | 12.50 | 12.50 | |
| Leaves | J. communis | n.d. | n.d. | 25.00 | n.d. | n.d. | n.d. |
| J. oxycedrus | n.d. | n.d. | 25.00 | n.d. | n.d. | n.d. | |
| Controls | Chloramphenicol | − | − | − | − | − | − |
| Solvent | + | + | + | + | + | + | |
Disclaimer/Publisher’s Note: The statements, opinions and data contained in all publications are solely those of the individual author(s) and contributor(s) and not of MDPI and/or the editor(s). MDPI and/or the editor(s) disclaim responsibility for any injury to people or property resulting from any ideas, methods, instructions or products referred to in the content. |
© 2024 by the authors. Licensee MDPI, Basel, Switzerland. This article is an open access article distributed under the terms and conditions of the Creative Commons Attribution (CC BY) license (https://creativecommons.org/licenses/by/4.0/).
Share and Cite
Mërtiri, I.; Păcularu-Burada, B.; Stănciuc, N. Phytochemical Characterization and Antibacterial Activity of Albanian Juniperus communis and Juniperus oxycedrus Berries and Needle Leaves Extracts. Antioxidants 2024, 13, 345. https://doi.org/10.3390/antiox13030345
Mërtiri I, Păcularu-Burada B, Stănciuc N. Phytochemical Characterization and Antibacterial Activity of Albanian Juniperus communis and Juniperus oxycedrus Berries and Needle Leaves Extracts. Antioxidants. 2024; 13(3):345. https://doi.org/10.3390/antiox13030345
Chicago/Turabian StyleMërtiri, Ilir, Bogdan Păcularu-Burada, and Nicoleta Stănciuc. 2024. "Phytochemical Characterization and Antibacterial Activity of Albanian Juniperus communis and Juniperus oxycedrus Berries and Needle Leaves Extracts" Antioxidants 13, no. 3: 345. https://doi.org/10.3390/antiox13030345
APA StyleMërtiri, I., Păcularu-Burada, B., & Stănciuc, N. (2024). Phytochemical Characterization and Antibacterial Activity of Albanian Juniperus communis and Juniperus oxycedrus Berries and Needle Leaves Extracts. Antioxidants, 13(3), 345. https://doi.org/10.3390/antiox13030345

